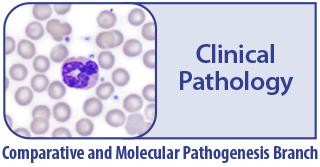
clinical pathology

Much of the work carried out by DTT is in support of the National Toxicology Program (NTP), an interagency partnership of the Food and Drug Administration, National Institute for Occupational Safety and Health, and NIEHS.
Hematology, Clinical Chemistry, Urinalysis & Cytology

Michelle C. Cora, D.V.M., D.A.C.V.P.
[email protected]
Research Summary
The Clinical Pathology Group provides technical, collaborative and consultative clinical pathology support for investigators at NIEHS and the Division of Translational Toxicology (DTT). The laboratory provides basic services in hematology, clinical chemistry, urinalysis and cytology with capabilities to analyze both animal and human specimens. Special assays also have been performed including the determination of hormone, growth factor, prostaglandin and chemokine/cytokine concentrations; bone marrow cytology; methemoglobin concentration; and cholinesterase and isoenzyme evaluations. Over time, considerable efforts regarding acquisition of equipment, upgrading standard operating procedures, implementing appropriate data management, quality control, quality assurance, and proficiency testing programs have been made to ensure that these laboratories continue to provide high quality clinical pathology services. For over two decades, the Clinical Pathology Group has been a valuable resource for the Institute.
Michelle Cora, D.V.M., D.A.C.V.P., leads the Clinical Pathology Group within the Comparative and Molecular Pathogenesis Branch (CMPB). She earned her Doctor of Veterinary Medicine (DVM) degree from University of Illinois; residency training in veterinary clinical pathology from North Carolina State University, College of Veterinary Medicine (NCSU-CVM) and training in toxicological clinical pathology as a DTT toxicological clinical pathology research fellow. She has been a Diplomate of the American College of Veterinary Pathologists since 2011.
Scientists & Staff

Michelle C. Cora, D.V.M., D.A.C.V.P.
[email protected]


Recent Publications
- National Toxicology Program. Toxicity study of Stachybotrys chartarum (CASRN 67892-26-6) administered by inhalation to B6C3F1/N mice. Toxicity report series. 2024 Oct [Epub ahead of print]. [ AbstractNational Toxicology Program. Toxicity study of Stachybotrys chartarum (CASRN 67892-26-6) administered by inhalation to B6C3F1/N mice. Toxicity report series. 2024 Oct ]
- Panzacchi S, Belpoggi F, Bua L, Bucher J, Cora M, De Angelis L, Falcioni L, Gnudi F, Mandrioli D, Manservigi M, Manzoli I, Masten S, Menghetti I, Mutlu E, Roberts G, Shipkowski K, Sills R, Stout M, Strollo V, Tibaldi E, Tracy J, Vornoli A, Waidyanatha S. NIEHS Report on the Toxicity Studies of Nicotine Bitartrate Dihydrate (CASRN 6019-06-3) Administered in Drinking Water to Sprague Dawley Rats and Swiss Mice: NIEHS Report 11 NIEHS Report Series. 2024 Oct [Epub ahead of print]. [ AbstractPanzacchi S, Belpoggi F, Bua L, Bucher J, Cora M, De Angelis L, Falcioni L, Gnudi F, Mandrioli D, Manservigi M, Manzoli I, Masten S, Menghetti I, Mutlu E, Roberts G, Shipkowski K, Sills R, Stout M, Strollo V, Tibaldi E, Tracy J, Vornoli A, Waidyanatha S. NIEHS Report on the Toxicity Studies of Nicotine Bitartrate Dihydrate (CASRN 6019-06-3) Administered in Drinking Water to Sprague Dawley Rats and Swiss Mice: NIEHS Report 11 NIEHS Report Series. 2024 Oct ]
- National Toxicology Program. Toxicology and carcinogenesis studies of black cohosh root extract (CASRN 84776-26-1) administered by gavage to Sprague Dawley (Hsd:Sprague Dawley SD) rats and female B6C3F1/N mice. National Toxicology Program technical report series. 2023 Dec [Epub ahead of print]. [ AbstractNational Toxicology Program. Toxicology and carcinogenesis studies of black cohosh root extract (CASRN 84776-26-1) administered by gavage to Sprague Dawley (Hsd:Sprague Dawley SD) rats and female B6C3F1/N mice. National Toxicology Program technical report series. 2023 Dec ]
- National Toxicology Program. Toxicology and carcinogenesis studies of an isomeric mixture of tris(chloropropyl) phosphate administered in feed to Sprague Dawley (Hsd:Sprague Dawley SD) rats and B6C3F1/N mice. National Toxicology Program technical report series. 2023 Jun [Epub ahead of print]. [ AbstractNational Toxicology Program. Toxicology and carcinogenesis studies of an isomeric mixture of tris(chloropropyl) phosphate administered in feed to Sprague Dawley (Hsd:Sprague Dawley SD) rats and B6C3F1/N mice. National Toxicology Program technical report series. 2023 Jun ]
- Izawa T, Travlos G, Cortes R, Clayton N, Sills R, Pandiri A. Absence of Increased Susceptibility to Acetaminophen-Induced Liver Injury in a Diet-Induced NAFLD Mouse Model. Toxicologic pathology. 2023 Apr;51(3):112-125. [ AbstractIzawa T, Travlos G, Cortes R, Clayton N, Sills R, Pandiri A. Absence of Increased Susceptibility to Acetaminophen-Induced Liver Injury in a Diet-Induced NAFLD Mouse Model. Toxicologic pathology. 2023 Apr ]


